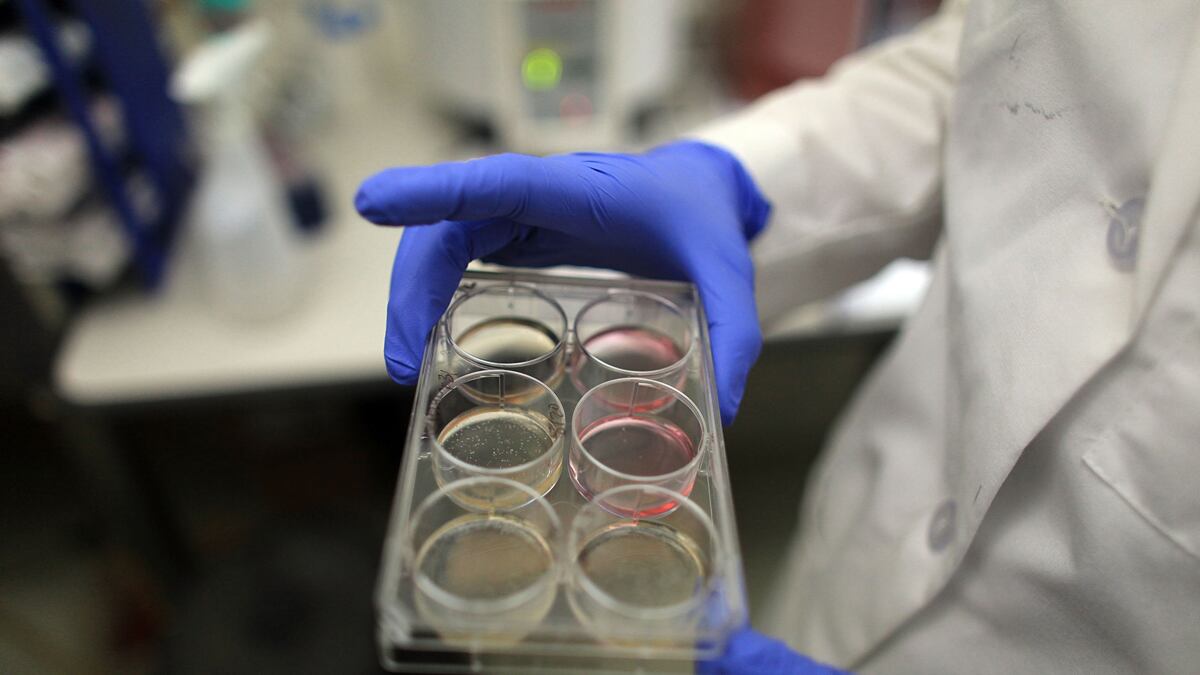
cheats/2011/07/27/obama-wins-stem-cell-suit/stem-cells-obama-cheat_afpi1w

A federal judge threw out a lawsuit against the Obama administration arguing that federal funding for stem-cell research violated a 1996 law prohibiting government dollars from going to work that harms embryos. A Boston biological engineer brought the suit, which a Reagan-appointed judge had allowed to proceed. But the U.S. Court of Appeals overruled the judge, allowing the National Institutes of Health to continue research on embryos harvested long ago through private funding.
Read it at Politico